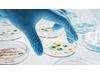

- Home
- Companies
- Environmental Specialties, LLC an EMCOR ...
- Products
- ESL - Walk-in Warm Rooms

ESL - Walk-in Warm Rooms
The ideal solution for applications like incubation or ramping, warm rooms offer stable, reliable performance year after year. Varying in size from small step-in units to large stability storage areas with multiple air handlers—and with a range of temperatures from +10°C to over 70°C (with uniformity of ± 0.5°C)—Environmental Specialties warm rooms can meet the complex demands of anyone seeking a high-quality testing environment.
The Environmental Specialties team is made up of skilled engineers with extensive warm room experience. They’re ready to meet the demands of clients seeking even the most complex, high-quality testing environments.
Our warm rooms are suitable for a wide range of industries and applications including:
- Insect rearing
- Sample preparation
- Production, lab, and packaging
- Hazardous material
- Ramping
- Media and chemical
- Chromatography and analytical separations
- Incubation
Our warm rooms are fully customizable to meet your exact specifications, including size, temperature, and electrical control system modifications. They combine maximum flexibility and the latest in advanced features with precise temperature and humidity control.
- Ranging in sizes from lab to incubator
- Temperature set-points between +10°C to +70°C
- Volumetric temperature uniformity (horizontal and vertical) of +/- 3°C
- Single point or variable set-point temperature control accuracy of +/-0.1°C
- N+N (2N) 100-percent mechanical redundancy systems with automatic switchover
- Rooms built with insulated metal structure
- Material choices available for corrosive or aggressive cleaning agents
- Design classifications available, including incubation and insect rearing
- Controls compliance with Food and Drug Administration Code of Federal Regulations Title 21 Section 11
- Standard controls can be integrated to building management and building automation systems
- Modular metal skinned panels with urethane insulation featuring “cam-locking” tongue-and-groove construction, as well as vinyl gasketed seams to provide moisture- and vapor-tight seal
- Self-supporting or building supported roof panel suspension
- Insulated panel finishes of stainless steel or embossed white galvanized steel
- Standard panel thickness of four inches
- Floor panel (if applicable):
- Stainless steel, galvanized steel, or diamond plate finishes
- Standard floor load rating of 600 pounds per square foot, with higher rating if necessary
- Factory Mutual (FM) 4880 fire rating available
- Lighting:
- Vapor-proof LED fixtures
- Standard, motion detected, or zoned lighting controls
- Controls:
- Proportional–integral–derivative (PID) or programmable logic controller (PLC)
- Optional redundancy
- Minimum one-year labor and materials with variable extended warranty available
- 24-hour duration
- Monitoring points ranging from 16 to 24 unloaded
- Validation available as an additional service, including installation qualification (IQ), operational qualification (OQ), and performance qualification (PQ)
- Master manual (engineering/design submittal)
- Recommended spare parts
- Major equipment datasheets
- As-built drawings and schematics
- Owner’s instructions
- Controls manual
- Equipment manual
- Warranty statements
- Field testing data
We can design our warm rooms to meet a variety of highly specialized requirements, including:
- ISO 5, Grade A or B
- ISO 6
- ISO 7, Grade B or C
- ISO 8, Grade C or D
- Explosion-safe Class 1 Division 2
- Outdoor construction
- Customer/project specific customizations